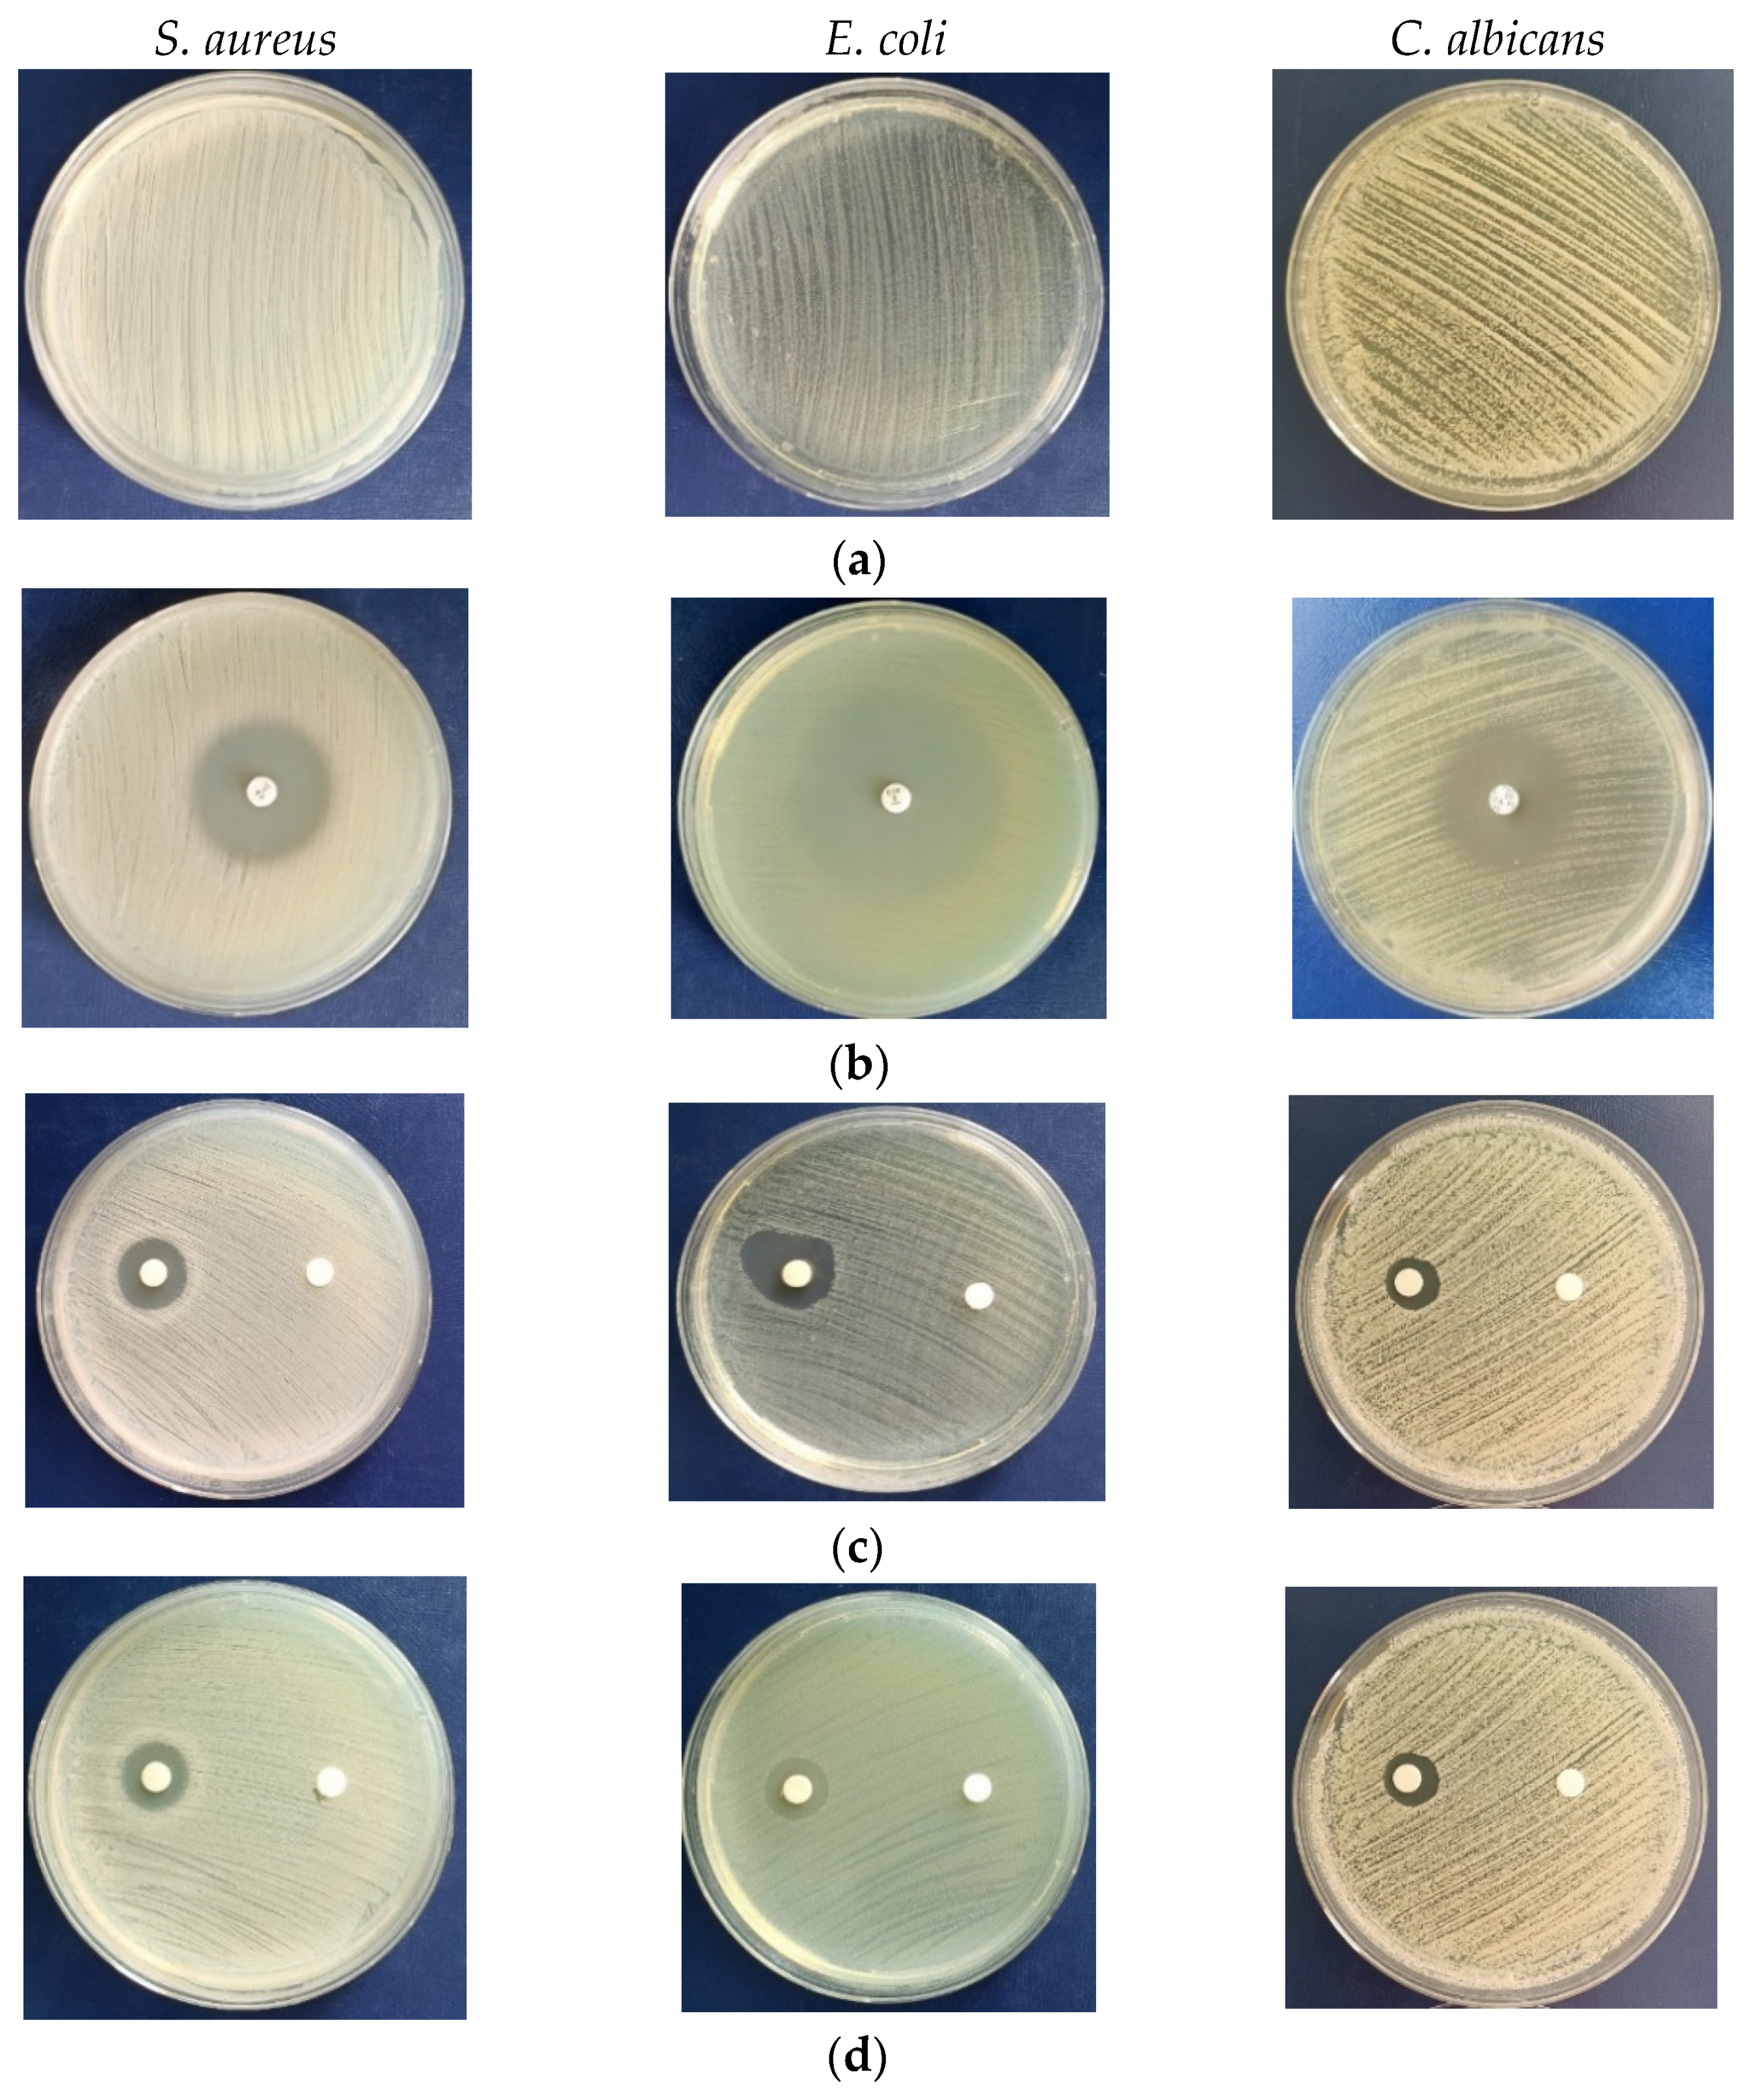
Jof 10 00798 g007a
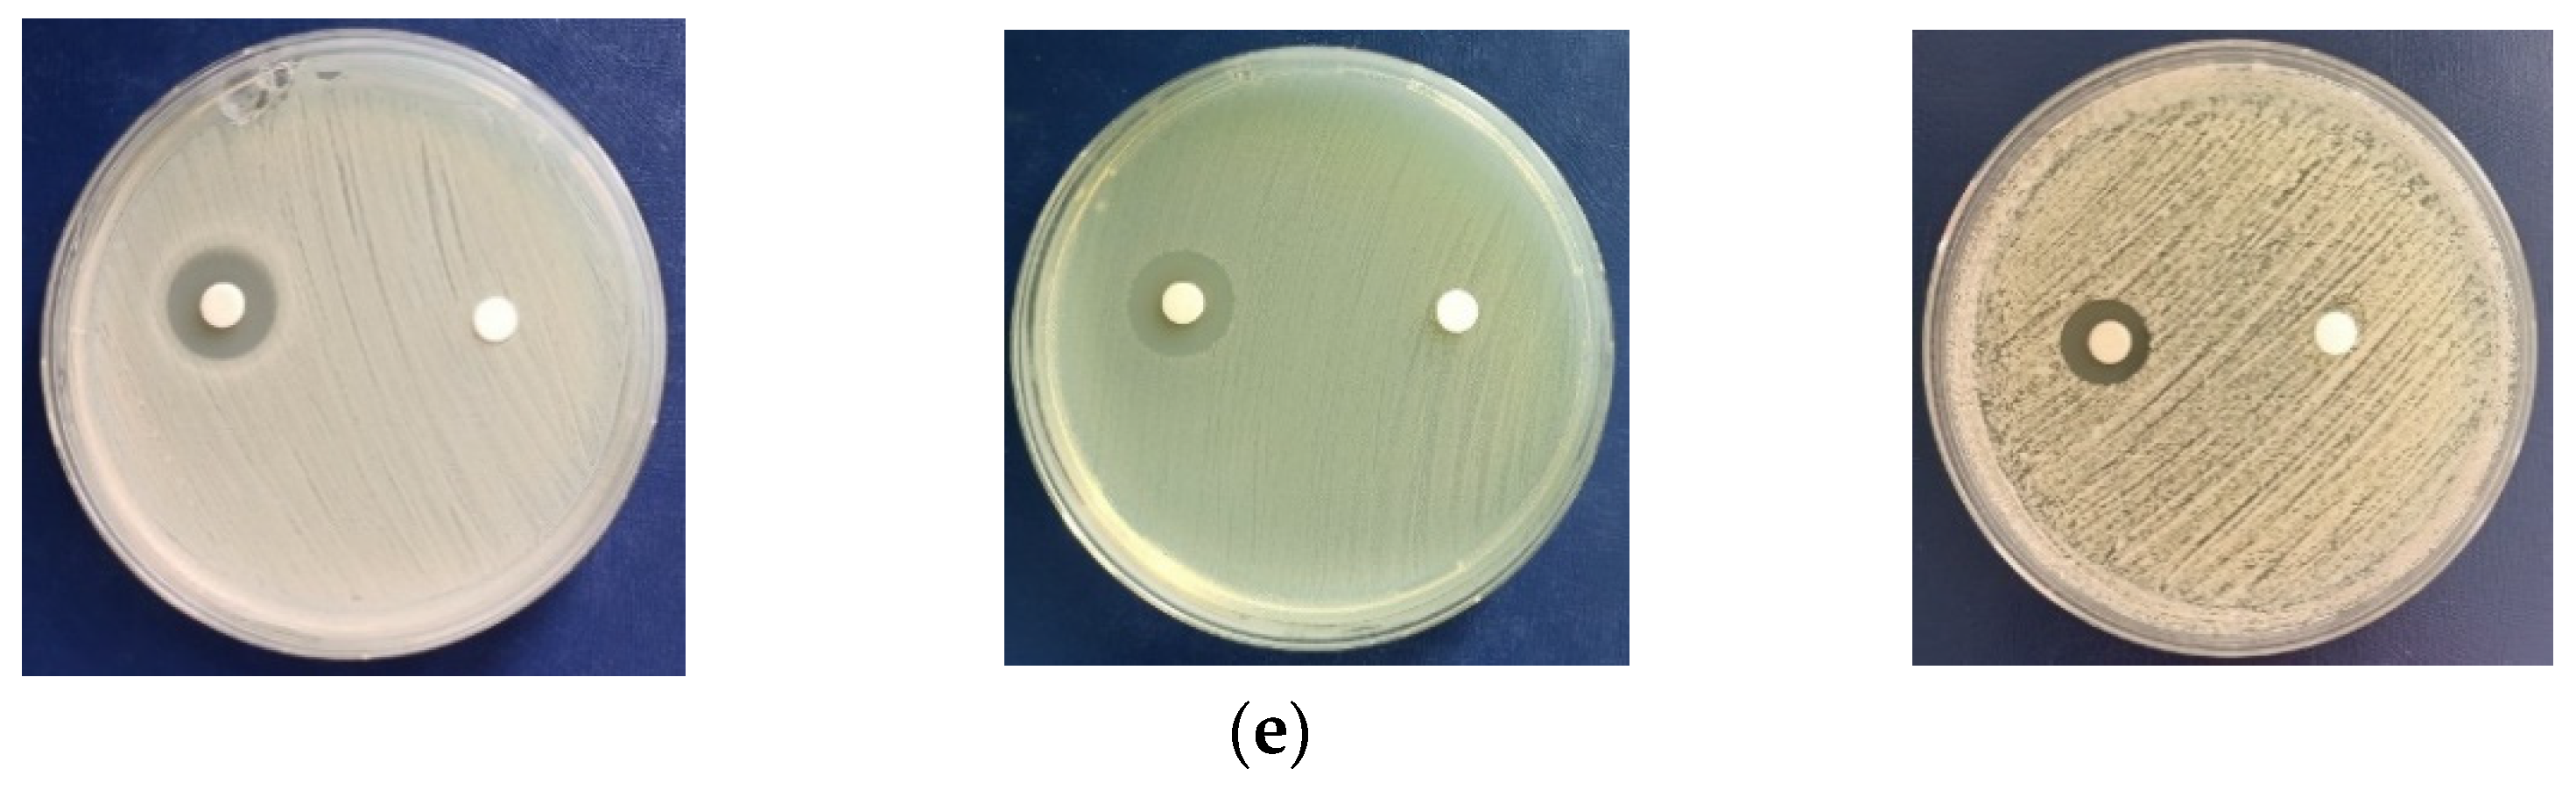
Jof 10 00798 g007b

Extracellular Biosynthesis, Characterization and Antimicrobial Activity of Silver Nanoparticles Synthesized by Filamentous Fungi
Abstract
1. Introduction
2. Materials and Methods
2.1. Fungal Isolates and Mycelial Growth
2.2. Preparation of AgNPs
2.3. Characterisation of the Biogenic Nanoparticles
2.4. Antimicrobial Activity
2.5. Minimum Inhibitory Concentration MIC Determination
2.6. Statistical Analysis
3. Results
3.1. Biosynthesis of AgNPs Visual Inspection
3.2. UV-Vis Spectra
3.3. SEM Analysis
3.4. FTIR Spectra
3.5. DLS and Zeta Potential
3.6. TEM Analysis
3.7. Antimicrobial Study
4. Discussion
5. Conclusions
Author Contributions
Funding
Institutional Review Board Statement
Informed Consent Statement
Data Availability Statement
Acknowledgments
Conflicts of Interest
References
- Jain, K.; Patel, A.S.; Pardhi, V.P.; Flora, S.J.S. Nanotechnology in Wastewater Management: A New Paradigm Towards Wastewater Treatment. Molecules 2021, 26, 1797. [Google Scholar] [CrossRef]
- Nakum, J.; Bhattacharya, D. Various Green Nanomaterials Used for Wastewater and Soil Treatment: A Mini-Review. Front. Environ. Sci. 2022, 9, 724814. [Google Scholar] [CrossRef]
- Rani, G.; Bala, A.; Ahlawat, R.; Nunach, A.; Chahar, S. Recent Advances in Synthesis of AgNPs and Their Role in Degradation of Organic Dyes. Comment. Inorg. Chem. 2024, 1–29. [Google Scholar] [CrossRef]
- Azeez, L.; Lateef, A.; Olabode, O. An overview of biogenic metallic nanoparticles for water treatment and purification: The state of the art. Water Sci. Technol. 2023, 88, 851–873. [Google Scholar] [CrossRef] [PubMed]
- Chakraborty, S.; Singh, A.; Roychoudhury, A. Biogenic nanoparticles and generation of abiotic stress-resilient plants: A new approach for sustainable agriculture. Plant Stress 2022, 6, 100117. [Google Scholar] [CrossRef]
- Wahid, I.; Rani, R.; Kumari, S.; Ahmad, R.; Hussain, S.J.; Alamari, S.T.; Tripathy, N.; Khan, I.R. Biosynthesized gold nanoparticles-maintained nitrogen metabolism, nitric oxide synthesis, ions balance, and stabilizes the defence systems to improve salt stress tolerance in wheat. Chemosphere 2022, 287, 132142. [Google Scholar] [CrossRef] [PubMed]
- Periakaruppan, R.; Romanovski, V.; Thirumalaisamy, S.K.; Palanimuthu, V.; Sampath, M.P.; Anilkumar, A.; Sivaraj, D.K.; Ahamed, N.A.N.; Murugesan, S.; Chandrasekar, D.; et al. Innovations in Modern Nanotechnology for the Sustainable Production of Agriculture. Chem. Eng. 2023, 7, 61. [Google Scholar] [CrossRef]
- Adeyemi, J.O.; Fawole, O.A. Metal-Based Nanoparticles in Food Packaging and Coating Technologies: A Review. Biomolecules 2023, 13, 1092. [Google Scholar] [CrossRef]
- Kumar, A.; Kumar, A.; Vats, C.; Sangwan, P.; Kumar, V.; Abhineet; Chauhan, P.; Chauhan, R.S.; Chaudhary, K. Recent insights into metallic nanoparticles in shelf-life extension of agrifoods: Properties, green synthesis, and major applications. Front. Sustain. Food Syst. 2022, 6, 1025342. [Google Scholar] [CrossRef]
- Singh, A.; Gautam, P.K.; Verma, A.; Singh, V.; Shivapriya, P.M.; Shivalkar, S.; Sahoo, A.K.; Samanta, S.K. Green synthesis of metallic nanoparticles as effective alternatives to treat antibiotics resistant bacterial infections: A review. Biotechnol. Rep. 2020, 25, e00427. [Google Scholar] [CrossRef]
- Ribeiro, A.I.; Dias, A.M.; Zille, A. Synergistic Effects Between Metal Nanoparticles and Commercial Antimicrobial Agents: A Review. ACS Appl. Nano Mater. 2022, 5, 3030–3064. [Google Scholar] [CrossRef] [PubMed]
- Verma, R.K.; Nagar, V.; Sharma, A.; Mavry, B.; Kumari, P.; Lohar, S.; Singhal, A.; Prajapati, M.K.; Singh, A.; Awasthi, K.K.; et al. Green Synthesized Nanoparticles Targeting Antimicrobial Activities. Biointerface Res. Appl. Chem. 2023, 13, 469. [Google Scholar]
- Crisan, C.M.; Mocan, T.; Manolea, M.; Lasca, L.I.; Tabaran, F.-A.; Mocan, L. Review on Silver Nanoparticles as a Novel Class of Antibacterial Solutions. Appl. Sci. 2021, 11, 1120. [Google Scholar] [CrossRef]
- Ghosh, S.; Ahmad, R.; Zeyaullah, M.; Khare, S.K. Microbial Nano-Factories: Synthesis and Biomedical Applications. Front. Chem. 2021, 16, 626834. [Google Scholar] [CrossRef]
- Da Silva, R.T.P.; de Barros, H.R.; Sandrini, D.M.F.; Córdoba de Torresi, S.I. Stimuli-Responsive Regulation of Biocatalysis through Metallic Nanoparticle Interaction. Bioconjugate Chem. 2022, 33, 53–66. [Google Scholar] [CrossRef]
- Dikshit, P.K.; Kumar, J.; Das, A.K.; Sadhu, S.; Sharma, S.; Singh, S.; Gupta, P.K.; Kim, B.S. Green Synthesis of Metallic Nanoparticles: Applications and Limitations. Catalysts 2021, 11, 902. [Google Scholar] [CrossRef]
- Malathi, S.; Pakrudheen, I.; Narayana Kalkura, S.; Webster, T.J.; Balasubramanian, S. Disposable biosensors based on metal nanoparticles. Sens. Intern. 2022, 3, 100169. [Google Scholar] [CrossRef]
- Białas, K.; Moschou, D.; Marken, F.; Estrela, P. Electrochemical sensors based on metal nanoparticles with biocatalytic activity. Microchim. Acta 2022, 189, 172. [Google Scholar] [CrossRef]
- Abid, N.; Khan, A.M.; Shujait, S.; Chaudhary, K.; Ikram, M.; Imran, M.; Haider, J.; Khan, M.; Khan, Q.; Maqbool, M. Synthesis of nanomaterials using various top-down and bottom-up approaches, influencing factors, advantages, and disadvantages: A review. Adv. Colloid Interface Sci. 2022, 300, 102597. [Google Scholar] [CrossRef]
- Pineda, M.E.B.; Forero, L.M.L.; Sierra, C.A. Mycosynthesis of silver nanoparticles: A review. Biometals 2023, 36, 745–776. [Google Scholar] [CrossRef]
- Gong, X.; Jadhav, N.D.; Lonikar, V.V.; Kulkarni, A.N.; Zhang, H.; Sankapal, B.R.; Ren, J.; Xu, B.B.; Pathan, H.M.; Ma, Y.; et al. An overview of green synthesized silver nanoparticles towards bioactive antibacterial, antimicrobial and antifungal applications. Adv. Colloid Interface Sci. 2024, 323, 103053. [Google Scholar] [CrossRef] [PubMed]
- Miu, B.A.; Dinischiotu, A. New Green Approaches in Nanoparticles Synthesis: An Overview. Molecules 2022, 27, 6472. [Google Scholar] [CrossRef] [PubMed]
- Chopra, H.; Bibi, S.; Singh, I.; Hasan, M.M.; Khan, M.S.; Yousafi, Q.; Baig, A.A.; Rahman, M.M.; Islam, F.; Emran, T.B.; et al. Green Metallic Nanoparticles: Biosynthesis to Applications. Front. Bioeng. Biotechnol. 2022, 10, 874742. [Google Scholar] [CrossRef] [PubMed]
- Yadav, R.; Kumar, M.; Tomar, R.S. Revisiting the microbial biosynthesis of metal nanoparticles and their applications. J. Appl. Pharm. Sci. 2023, 13, 013–031. [Google Scholar] [CrossRef]
- Alfryyan, N.; Kordy, M.G.M.; Abdel-Gabbar, M.; Soliman, H.A.; Shaban, M. Characterization of the biosynthesized intracellular and extracellular plasmonic silver nanoparticles using Bacillus cereus and their catalytic reduction of methylene blue. Sci. Rep. 2022, 12, 12495. [Google Scholar] [CrossRef]
- Campaña, A.L.; Saragliadis, A.; Mikheenko, P.; Linke, D. Insights into the bacterial synthesis of metal nanoparticles. Front. Nanotechnol. 2023, 5, 1216921. [Google Scholar] [CrossRef]
- Kareem, E.A.A.; Oraibi, H.M.; Sultan, A.E. Synthesis and Characterization of Silver Nanoparticles: A Review. IHJPAS 2023, 36, 177–200. [Google Scholar] [CrossRef]
- Anjum, S.; Vyas, A.; Sofi, T. Fungi-mediated synthesis of nanoparticles: Characterization process and agricultural applications. J. Sci. Food Agric. 2023, 103, 4727–4741. [Google Scholar] [CrossRef]
- Guilger-Casagrande, M.; Lima, R. Synthesis of Silver Nanoparticles Mediated by Fungi: A Review. Front. Bioeng. Biotechnol. 2019, 7, 287. [Google Scholar] [CrossRef]
- Li, Q.; Liu, F.; Li, M.; Chen, C.; Gadd, G.M. Nanoparticle and nanomineral production by fungi. Fungal Biol. Rev. 2022, 41, 31–44. [Google Scholar] [CrossRef]
- Loshchinina, E.A.; Vetchinkina, E.P.; Kupryashina, M.A. Diversity of Biogenic Nanoparticles Obtained by the Fungi-Mediated Synthesis: A Review. Biomimetics 2023, 8, 1. [Google Scholar] [CrossRef] [PubMed]
- Ranjani, S.; Shariq, A.M.; Mohd, A.; Senthil, K.N.; Ruckmani, K.; Hemalatha, S. Synthesis, characterization and applications of endophytic fungal nanoparticles. Inorg. Nano-Met. Chem. 2021, 51, 280–287. [Google Scholar] [CrossRef]
- Šebesta, M.; Vojtková, H.; Cyprichová, V.; Ingle, A.P.; Urík, M.; Kolencík, M. Mycosynthesis of Metal-Containing Nanoparticles—Synthesis by Ascomycetes and Basidiomycetes and Their Application. Int. J. Mol. Sci. 2023, 24, 304. [Google Scholar] [CrossRef] [PubMed]
- Arora, S.; Latwal, M.; Bahukhandi, K.D.; Kumar, D.; Vemulapalli, T.; Egutoori, S.; Siddiqui, N.A. Greener Approach to Metallic Nanoparticles: A Review. Nat. Environ. Pollut. Technol. 2021, 20, 481–490. [Google Scholar] [CrossRef]
- Pasha, A.; Kumbhakar, D.V.; Sana, S.S.; Ravinder, D.; Lakshmi, B.V.; Kalangi, S.K.; Pawar, S.C. Role of Biosynthesized Ag-NPs using Aspergillus niger (MK503444.1) in Antimicrobial, Anti-Cancer and Anti- Angiogenic Activities. Front. Pharmacol. 2022, 12, 812474. [Google Scholar] [CrossRef]
- Fouda, A.; Awad, M.A.; AL-Faifi, Z.E.; Gad, M.E.; Al-Khalaf, A.A.; Yahya, R.; Hamza, M.F. Aspergillus flavus-Mediated Green Synthesis of Silver Nanoparticles and Evaluation of Their Antibacterial, Anti-Candida, Acaricides, and Photocatalytic Activities. Catalysts 2022, 12, 462. [Google Scholar] [CrossRef]
- Govindappa, M.; Lavanya, M.; Aishwarya, P.; Pai, K.; Lunked, P.; Hemashekhar, B.; Arpitha, B.M.; Ramachandra, Y.L.; Raghavendra, V.B. Synthesis and Characterization of Endophytic Fungi, Cladosporium perangustum Mediated Silver Nanoparticles and their Antioxidant, Anticancer and Nano-toxicological Study. BioNanoSci 2020, 10, 928–941. [Google Scholar] [CrossRef]
- Hulikere, M.M.; Joshi, C.G. Characterization, antioxidant and antimicrobial activity of silver nanoparticles synthesized using marine endophytic fungus Cladosporium cladosporioides. Process Biochem. 2019, 82, 199–204. [Google Scholar] [CrossRef]
- Yassin, M.A.; Elgorban, A.M.; El-Samawaty, A.E.M.A.; Almunqedhi, B.M.A. Biosynthesis of silver nanoparticles using Penicillium verrucosum and analysis of their antifungal activity. Saudi J. Biol. Sci. 2021, 28, 2123–2127. [Google Scholar] [CrossRef]
- Gupta, P.; Rai, N.; Verma, A.; Saikia, D.; Singh, S.P.; Kumar, R.; Singh, S.K.; Kumar, D.; Gautam, V. Green-Based Approach to Synthesize Silver Nanoparticles Using the Fungal Endophyte Penicillium oxalicum and Their Antimicrobial, Antioxidant, and In Vitro Anticancer Potential. ACS Omega 2022, 7, 46653–46673. [Google Scholar] [CrossRef]
- Rai, M.; Bonde, S.; Golinska, P.; Trzcińska-Wencel, J.; Gade, A.; Abd-Elsalam, K.A.; Shende, S.; Gaikwad, S.; Ingle, A.P. Fusarium as a Novel Fungus for the Synthesis of Nanoparticles: Mechanism and Applications. J. Fungi 2021, 7, 139. [Google Scholar] [CrossRef] [PubMed]
- Nayak, B.K.; Prabhakar, V.; Nanda, A. Myco-Facilitated Biosynthesis of Nano-Silver from Wasp Nest Fungus, Paecilomyces variotii, and Its Antimicrobial Activity Against MTCC Strains. Front. Microbiol. 2021, 13, 841666. [Google Scholar] [CrossRef] [PubMed]
- Tomah, A.A.; Zhang, Z.; Alamer, I.S.A.; Khattak, A.A.; Ahmed, T.; Hu, M.; Wang, D.; Xu, L.; Li, B.; Wang, Y. The Potential of Trichoderma-Mediated Nanotechnology Application in Sustainable Development Scopes. Nanomaterials 2023, 13, 2475. [Google Scholar] [CrossRef] [PubMed]
- Ramírez-Valdespino, C.A.; Orrantia-Borunda, E. Trichoderma and Nanotechnology in Sustainable Agriculture: A Review. Front. Fungal Biol. 2021, 2, 764675. [Google Scholar] [CrossRef]
- Iranmanesh, S.; Shahidi Bonjar, G.H.; Baghizadeh, A. Study of the biosynthesis of gold nanoparticles by using several saprophytic fungi. SN Appl. Sci. 2020, 2, 1851. [Google Scholar] [CrossRef]
- Osorio-Echavarría, J.; Osorio-Echavarría, J.; Ossa-Orozco, C.P.; Gómez-Vanegas, N.A. Synthesis of silver nanoparticles using white-rot fungus Anamorphous Bjerkandera sp. R1: Influence of silver nitrate concentration and fungus growth time. Sci. Rep. 2021, 11, 3842. [Google Scholar] [CrossRef]
- Xu, F.; Li, Y.; Zhao, X.; Liu, G.; Pang, B.; Liao, N.; Li, H.; Shi, J. Diversity of fungus-mediated synthesis of gold nanoparticles: Properties, mechanisms, challenges, and solving methods. Crit. Rev. Biotechnol. 2024, 44, 924–940. [Google Scholar] [CrossRef]
- Ibrahim, S.; Ahmad, Z.; Manzoor, M.Z.; Mujahid, M.; Faheem, Z.; Adnan, A. Optimization for biogenic microbial synthesis of silver nanoparticles through response surface methodology, characterization, their antimicrobial, antioxidant, and catalytic potential. Sci. Rep. 2021, 11, 770. [Google Scholar] [CrossRef]
- Constantin, M.; Răut, I.; Suica-Bunghez, R.; Firinca, C.; Radu, N.; Gurban, A.M.; Preda, S.; Alexandrescu, E.; Doni, M.; Jecu, L. Ganoderma lucidum-Mediated Green Synthesis of Silver Nanoparticles with Antimicrobial Activity. Materials 2023, 16, 4261. [Google Scholar] [CrossRef]
- Constantin, M.; Raut, I.; Gurban, A.-M.; Doni, M.; Radu, N.; Alexandrescu, E.; Jecu, L. Exploring the Potential. Applications of Paecilomyces lilacinus 112. App. Sci. 2022, 12, 7572. [Google Scholar] [CrossRef]
- Abeer, A.; Abd El, A.; Asem, A.M.; Zohair, M.M.; Soliman, A.A.F. Statistically controlled biogenesis of silver nano-size by Penicillium chrysogenum MF318506 for biomedical application. Biocatal. Agric. Biotechnol. 2020, 25, 101592. [Google Scholar] [CrossRef]
- Guo, Y.; Song, G.; Sun, M.; Wang, J.; Wang, Y. Prevalence and Therapies of Antibiotic-Resistance in Staphylococcus aureus. Front. Cell. Infect. Microbiol. 2020, 10, 107. [Google Scholar] [CrossRef] [PubMed]
- Tomah, A.A.; Abd Alamer, I.S.; Li, B.; Zhang, J.-Z. Mycosynthesis of Silver Nanoparticles Using Screened Trichoderma Isolates and Their Antifungal Activity against Sclerotinia sclerotiorum. Nanomaterials 2020, 10, 1955. [Google Scholar] [CrossRef] [PubMed]
- Raut, I.; Calin, M.; Capra, L.; Gurban, A.-M.; Doni, M.; Radu, N.; Jecu, L. Cladosporium sp. Isolate as Fungal Plant Growth Promoting Agent. Agronomy 2021, 11, 392. [Google Scholar] [CrossRef]
- Braz, V.S.; Melchior, K.; Moreira, C.G. Escherichia coli as a Multifaceted Pathogenic and Versatile Bacterium. Front. Cell Infect. Microbiol. 2020, 10, 548492. [Google Scholar] [CrossRef]
- Talapko, J.; Juzbašić, M.; Matijevic, T.; Pustijanac, E.; Bekic, S.; Kotris, I.; Škrlec, I. Candida albicans—The Virulence Factors and Clinical Manifestations of Infection. J. Fungi 2021, 7, 79. [Google Scholar] [CrossRef]
- Dara, P.K.; Mahadevan, R.; Digita, P.; Visnuvinayagam, S.; Kumar, L.R.; Mathew, S.; Ravishankar, C.N.; Anandan, R.J.S.A.S. Synthesis and biochemical characterization of silver nanoparticles grafted chitosan (chi-ag-NPs): In Vitro studies on antioxidant and antibacterial applications. SN Appl. Sci. 2020, 2, 1–12. [Google Scholar] [CrossRef]
- Li, Y.; Liao, Q.; Hou, W.; Qin, L. Silver-Based Surface Plasmon Sensors: Fabrication and Applications. Int. J. Mol. Sci. 2023, 24, 4142. [Google Scholar] [CrossRef]
- Isaq, M.; Ramachandra, Y.L.; Rai, R.S.; Chavan, A.; Sekar, R.; Lee, M.J.; Somu, P. Biogenic synthesized silver nanoparticles using fungal endophyte Cladosporium oxysporum of Vateria indica induce apoptosis in human colon cancer cell line via elevated intracellular ROS generation and cell cycle arrest. J. Mol. Liq. 2023, 386, 122601. [Google Scholar] [CrossRef]
- Zhu, Y.; Hu, H.; Qiao, M.; Zhao, L.; Dong, C. Penicillium polonicum-mediated green synthesis of silver nanoparticles: Unveiling antimicrobial and seed germination advancements. Heliyon 2024, 10, e28971. [Google Scholar] [CrossRef]
- Mourdikoudis, S.; Pallares, R.M.; Thanh, N.T.K. Characterization techniques for nanoparticles: Comparison and complementarity upon studying nanoparticle properties. Nanoscale 2018, 10, 12871. [Google Scholar] [CrossRef] [PubMed]
- Liaqat, N.; Jahan, N.; Ur-Rahman, K.; Anwar, T.; Quresh, H. Green synthesized silver nanoparticles: Optimization, characterization, antimicrobial activity, and cytotoxicity study by hemolysis assay. Front. Chem. 2022, 10, 952006. [Google Scholar] [CrossRef]
- Ameen, F.; Al-Homaidan, A.A.; Al-Sabri, A.; Almansob, A.; Alnandhar, S. Anti-oxidant, anti-fungal and cytotoxic effects of silver nanoparticles synthesized using marine fungus Cladosporium halotolerans. Appl. Nanosci. 2023, 13, 623–631. [Google Scholar] [CrossRef]
- Ingle, P.; Kamble, K.; Golinska, P.; Rai, M.; Gade, A. Chapter 12. Techniques for Characterization of Biologically Synthesized Nanoparticles by Fungi. In Mycosynthesis of Nanomaterials. Perspectives and Challenges, 1st ed.; Rai, M., Golinska, P., Eds.; CRC Press Taylor & Francis Group: Boca Raton, FL, USA, 2023. [Google Scholar]
- Smith, H.; Murphy, S.D.R. Target directed identification of natural bioactive compounds from filamentous fungi. Food Chem. 2023, 405, 134743. [Google Scholar] [CrossRef] [PubMed]
- Cui, X.; Zhong, Z.; Xia, R.; Liu, X.; Qin, L. Biosynthesis optimization of silver nanoparticles (AgNPs) using Trichoderma longibranchiatum and biosafety assessment with silkworm (Bombyx mori). Arab. J. Chem. 2022, 15, 104142. [Google Scholar] [CrossRef]
- Qiao, Z.P.; Wang, M.Y.; Liu, J.F.; Wang, Q.Z. Green synthesis of silver nanoparticles using a novel endophytic fungus Letendraea sp. WZ07: Characterization and evaluation of antioxidant, antibacterial and catalytic activities (3-in-1 system). Inorg. Chem. Commun. 2022, 138, 109301. [Google Scholar] [CrossRef]
- Mudalige, T.; Qu, H.; Van Haute, D.; Ansar, S.M.; Paredes, A.; Ingle, T. Chapter 11—Characterization of Nanomaterials: Tools and Challenges. In Nanomaterials for Food Applications, Micro and Nano Technologies; Elsevier: Amsterdam, The Netherlands, 2019; pp. 313–353. [Google Scholar] [CrossRef]
- Samuel, M.S.; Jose, S.; Selvarajan, E.; Mathimani, T.; Pugazhendhi, A. Biosynthesized silver nanoparticles using Bacillus amyloliquefaciens: Application for cytotoxicity effect on A549 cell line and photocatalytic degradation of p-nitrophenol. J. Photochem. Photobiol. B Biol. 2020, 202, 111642. [Google Scholar] [CrossRef]
- El-Ansary, A.E.; Omran, A.A.A.; Mohamed, H.I.; El-Mahdy, O.M. Green synthesized silver nanoparticles mediated by Fusarium nygamai isolate AJTYC1: Characterizations, antioxidant, antimicrobial, anticancer, and photocatalytic activities and cytogenetic effects. Environ. Sci. Pollut. Res. 2023, 30, 100477–100499. [Google Scholar] [CrossRef]
- Elkady, F.M.; Hashem, A.H.; Salem, S.S.; El-Sayyad, G.S.; Tawab, A.A.; Alkherkhisy, M.M.; Abdulrahman, M.S. Unveiling biological activities of biosynthesized starch/silver-selenium nanocomposite using Cladosporium cladosporioides CBS 174.62. BMC Microbiol. 2024, 24, 78. [Google Scholar] [CrossRef]
- Ghasemi, S.; Dabirian, S.; Kariminejad, F.; Koohi, D.E.; Nemattalab, M.; Majidimoghadam, S.; Zamanai, E.; Yousefbeyk, F. Process optimization for green synthesis of silver nanoparticles using Rubus discolor leaves extract and its biological activities against multi-drug resistant bacteria and cancer cells. Sci. Rep. 2024, 14, 4130. [Google Scholar] [CrossRef]
- Filippov, S.K.; Khusnutdinov, R.; Murmiliuk, A.; Inam, W.; Zakharova, L.Y.; Zhang, Z.; Khutoryanskiy, V.V. Dynamic light scattering and transmission electron microscopy in drug delivery: A roadmap for correct characterization of nanoparticles and interpretation of results. Mater. Horiz. 2023, 10, 5354–5370. [Google Scholar] [CrossRef] [PubMed]
- Duran, N.; De Jesus, M.B.; Favaro, W.J.; Nakazato, G. Chapter 13 Mechanism of Synthesis of Metal Nanoparticles by Fungi. In Mycosynthesis of Nanomaterials. Perspectives and Challenges, 1st ed.; Rai, M., Golinska, P., Eds.; CRC Press Taylor & Francis Group: Boca Raton, FL, USA, 2023. [Google Scholar]
- Abd-Elsalam, K.A. Special Issue: Fungal Nanotechnology. J. Fungi 2021, 7, 583. [Google Scholar] [CrossRef] [PubMed]
- Mussin, J.; Giusiano, G. Biogenic silver nanoparticles as antifungal agents. Front. Chem. 2022, 10, 1023542. [Google Scholar] [CrossRef] [PubMed]

| AgNPs Biosynthesized by Fungal Species | Diameter of Inhibition Zone (mm) * | ||
|---|---|---|---|
| Staphylococcus aureus | Escherichia coli | Candida albicans | |
| C. cladosporoides | 22.50 ± 0.50 | 20.83 ± 1.80 | 16.00 ± 1.00 |
| P. chrysogenum | 19.83 ± 0.20 | 19.33 ± 1.50 | 13.66 ± 0.20 |
| P. lilacinum | 21.66 ± 1.50 | 20.66 ± 2.00 | 14.08 ± 1.00 |
| AgNPs | Inhibition of Microorganisms Growth (%) | ||
|---|---|---|---|
| S. aureus | E. coli | C. albicans | |
| C. cladosporoides | 93.75 | 67.20 | 69.56 |
| P. chrysogenum | 82.62 | 62.35 | 62.10 |
| P. lilacinum | 90.25 | 66.65 | 64.00 |
Disclaimer/Publisher’s Note: The statements, opinions and data contained in all publications are solely those of the individual author(s) and contributor(s) and not of MDPI and/or the editor(s). MDPI and/or the editor(s) disclaim responsibility for any injury to people or property resulting from any ideas, methods, instructions or products referred to in the content. |
© 2024 by the authors. Licensee MDPI, Basel, Switzerland. This article is an open access article distributed under the terms and conditions of the Creative Commons Attribution (CC BY) license (https://creativecommons.org/licenses/by/4.0/).
Share and Cite
Răut, I.; Constantin, M.; Șuică-Bunghez, R.; Firincă, C.; Alexandrescu, E.; Gîfu, I.C.; Doni, M.; Zamfir, L.-G.; Gurban, A.-M.; Jecu, L. Extracellular Biosynthesis, Characterization and Antimicrobial Activity of Silver Nanoparticles Synthesized by Filamentous Fungi. J. Fungi 2024, 10, 798. https://doi.org/10.3390/jof10110798
Răut I, Constantin M, Șuică-Bunghez R, Firincă C, Alexandrescu E, Gîfu IC, Doni M, Zamfir L-G, Gurban A-M, Jecu L. Extracellular Biosynthesis, Characterization and Antimicrobial Activity of Silver Nanoparticles Synthesized by Filamentous Fungi. Journal of Fungi. 2024; 10(11):798. https://doi.org/10.3390/jof10110798
Chicago/Turabian StyleRăut, Iuliana, Mariana Constantin, Raluca Șuică-Bunghez, Cristina Firincă, Elvira Alexandrescu, Ioana Cătălina Gîfu, Mihaela Doni, Lucian-Gabriel Zamfir, Ana-Maria Gurban, and Luiza Jecu. 2024. "Extracellular Biosynthesis, Characterization and Antimicrobial Activity of Silver Nanoparticles Synthesized by Filamentous Fungi" Journal of Fungi 10, no. 11: 798. https://doi.org/10.3390/jof10110798
APA StyleRăut, I., Constantin, M., Șuică-Bunghez, R., Firincă, C., Alexandrescu, E., Gîfu, I. C., Doni, M., Zamfir, L.-G., Gurban, A.-M., & Jecu, L. (2024). Extracellular Biosynthesis, Characterization and Antimicrobial Activity of Silver Nanoparticles Synthesized by Filamentous Fungi. Journal of Fungi, 10(11), 798. https://doi.org/10.3390/jof10110798

